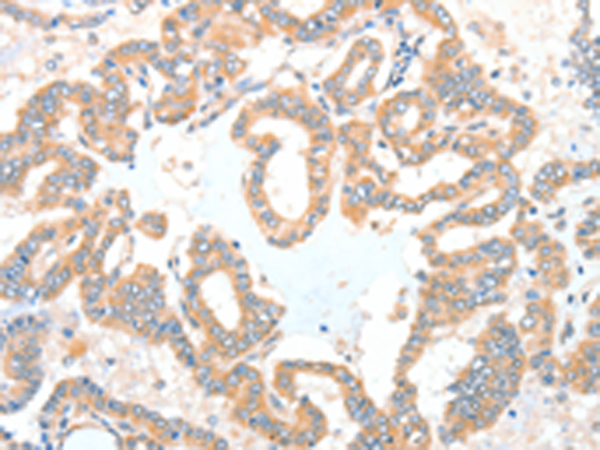

-
分类: 科研抗体货号: P07783别名: ADCK4; NPHS9应用: IHC反应种属: Human, Mouse, Rat
-
分类: 科研抗体货号: P07767别名: ACATE2; CGI-16; MTACT48; MT-ACT48应用: WB反应种属: Human, Mouse
-
分类: 科研抗体货号: P07798别名: HRB; RAB; RIP应用: WB,IHC反应种属: Human, Mouse, Rat
-
分类: 科研抗体货号: P07782别名:应用: IHC反应种属: Human, Mouse
-
分类: 科研抗体货号: P07792别名: AF9; YEATS3应用: IHC反应种属: Human, Mouse
-
分类: 科研抗体货号: P07797别名: CCP3应用: WB,IHC反应种属: Human, Mouse
-
分类: 科研抗体货号: P07781别名: M12.219应用: IHC反应种属: Human
-
分类: 科研抗体货号: P07791别名: AF10应用: WB反应种属: Human
-
分类: 科研抗体货号: P07796别名:应用: IHC反应种属: Human
-
分类: 科研抗体货号: P07780别名: KNO2; ADAMTS21应用: IHC反应种属: Human, Mouse

鄂公网安备42018502007531号
鄂公网安备42018502007531号

